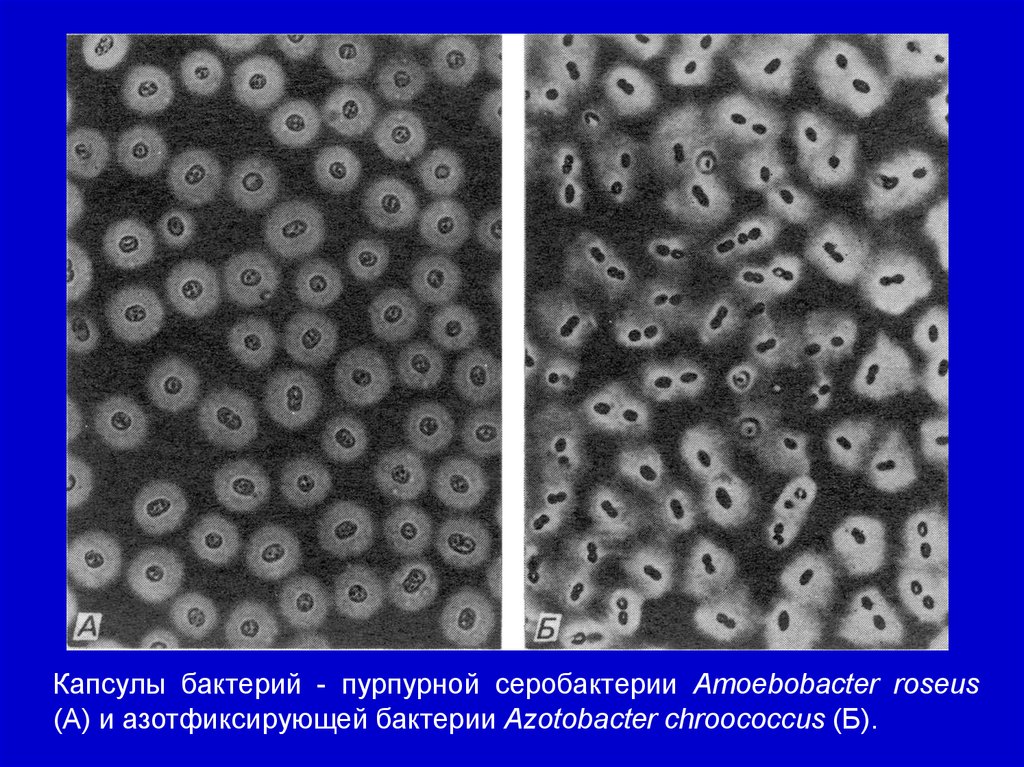

Строение и функции капсул бактерий
Позиция ствольщиков при тушении строительных лесов
Как разобрать брелок шкода
Офис 1progs
Даллес книга
Схема ядерного реактора майнкрафт
Эта прекрасная луна
Трусова последние выступления
Заправки на трассе м11 москва санкт петербург
Перевести целые десятичные числа 9 10
Краска для волос серджио
9 7 12 разделить на 1 4
Кошка которая похожа на рысь
Прошла тест на iq
Строение и функции капсул бактерий 116 фото